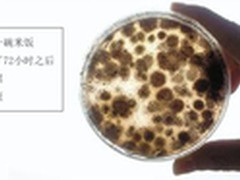
奥司汀空气净化器夏季使用怎么样?

奥司汀 夏季室内空气污染比室外重五倍
美国环境保护署历时5年调研发现,许多家庭室内的空气污染程度极高,是室外空气污染的数倍至数十倍;中国健康教育协会也曾发布报告指出,夏季是一年中的过敏高发时节,室内的空气污染要比户外高出四五倍。 ......
2016-07-27 关键字:三伏天奥司汀空气净化器除甲醛的效果
? 伴随着三伏天的到来,持续的闷热,加上多雨的天气,让空气中的细菌霉菌含量急剧增加!炎热的天气,偶尔的连续性降雨,是人们的出行机滤更低,待在屋里的时间会更长!伴随着就会出现这样那样的问题,比如“空调......
2016-07-22 关键字:美国奥司汀 夏季是治理甲醛的好时机
? 夏季天气炎热,气温会明显升高,雨水多,令人感到潮湿又闷热。由于季节特点,人们在这个时节易感到烦躁不安,闷热难耐,此时要注意调适心情,保持心情舒畅。可温度升高,也预示着现在是室内污染最为严重时期,......
2016-07-19 关键字:买空气净化器不止品牌 净化效果更重要
40-60平米的空间主要是有很多角落的细菌病毒。尤其是cadr值要比较大一点,使用的时候尽量可以挪动一下空气净化器,保证可以净化到房间的每个角落。但是最好不好选用加湿的和静电式的。加湿的容易滋生细菌产......
2016-07-18 关键字:家用空气净化器价格分析 哪个牌子好?
源自荷兰经典品牌的飞利浦,是闻名世界的一家家电企业。该品牌除了在照明灯、剃须刀等造诣很深之外,近年来也开始在空气净化器领域里探索。经过多年的沉淀,飞利浦渐渐有了自主的HEPA滤网和碳吸附技术,是空气净......
2016-07-15 关键字:奥司汀空气净化器:空调房变细菌房?
? 套用最近很火的美剧《权利的游戏》里面的一句话,不过得修改一下季节,“仲夏已至”室内除菌战,您准备好了吗?what?除菌,哪来的室内细菌?接下来请小编来为亲们一一解答。 首先您是否认知空......
2016-07-15 关键字:综合分析空气净化器十大排名品牌销量榜
调查显示,自从2016年3月我国空气净化器新国标颁布之后,绝大部分消费者都将新国标中提出的“三高一低”作为购买产品时的选购标准,从而使得部分依靠口号营销的品牌受到极大限制。此外,伴随着大量国际知名品牌......
2016-07-14 关键字:高端领域成空气净化器厂商发力重点
自2013年的爆发性增长以来,空气净化器已经进入了第四个年头,随着行业的不断规范与消费习惯的逐渐建立,空气净化器市场也进入稳步增长状态。而在当前消费升级的大势下,高端产品正成为拉动空气净化器市场的主......
2016-07-14 关键字:奥司汀空气净化器夏季使用怎么样?
? 炎热的夏季,最舒服的事情,莫过于躲在家中,开启空调纳凉。然而,有多少人在享受空调时,想到要定期对它进行清洗消毒?否则,空调将吹出看不见的细菌、真菌,甚至可以在72小时内,吹霉一碗白米饭! ......
2016-07-13 关键字:空气净化器能干嘛空气净化器哪个牌子好
在这个空气污染逐渐侵蚀我们生活各个角落的年代,我们开始担心起来了,担心空气污染会给我们带来什么样的伤害,带来什么样的疾病…然而,人们在面对困难的时候总会创造各种可行的办法解决生存问题,也许这就是人脑和......
2016-07-13 关键字: